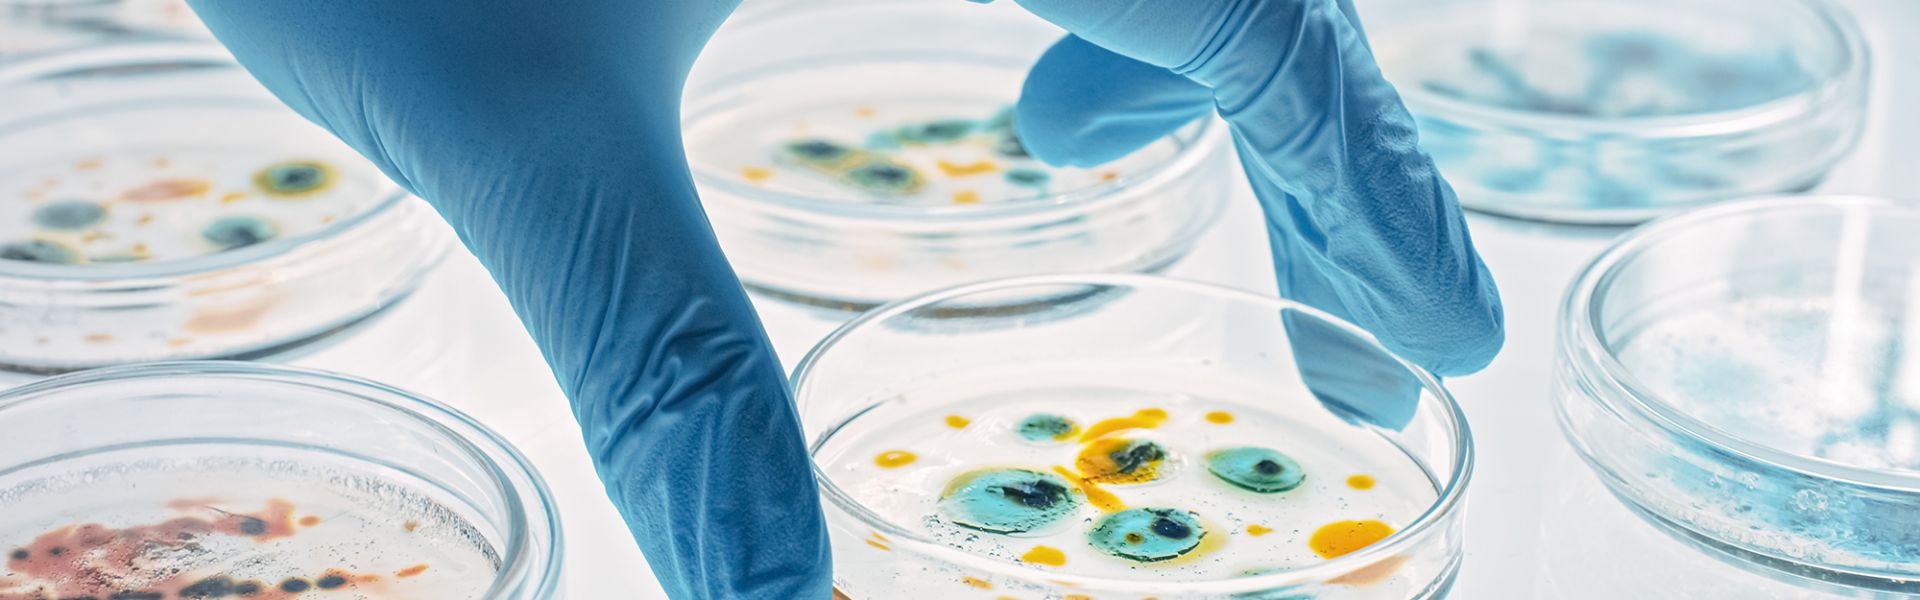

Antimicrobial resistance in animal health: a One Health approach
On 19 November 2024, ANSES is organising a one-day conference on antimicrobial resistance in animal health with a One Health approach. This event is part of World Antibiotic Awareness Week. The main annual results of the monitoring systems coordinated by ANSES will be presented at the event:
- Monitoring sales of veterinary medicinal products containing antimicrobials in France in 2023
This monitoring makes it possible to assess the exposure of domestic animals to antibiotics and other antimicrobials and to track changes in practices in different animal species. - European monitoring of animal antibiotic resistance
At national level, ANSES monitors the resistance of bacteria that can contaminate humans via foods of animal origin. The results are used to monitor developments at European level. - Résapath (French Surveillance Network for Antimicrobial Resistance in Pathogenic Bacteria of Animal Origin)
This network monitors trends in antimicrobial resistance in all domestic animal species in France.
The One Health dimension of antimicrobial resistance: let's talk about it!
Combating antimicrobial resistance by rethinking our practices requires a global approach based on the complementary viewpoints from different disciplines. At the event held in 2022 (in French) , ANSES tackled the cross-sectoral challenges of antimicrobial resistance by bringing together experts in human, animal and environmental health for a round table discussion.
This year, in order to continue the conversation, ANSES is inviting experts in the human and social sciences for a discussion of the One Health and antimicrobial resistance concept.
This event will be of interest to scientists, decision-makers and professionals in the field.


